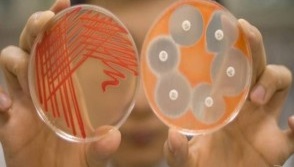

رییس مرکز تحقیقات مقاومت های میکروبی دانشگاه علوم پزشکی مشهد، گفت: : مرکز تحقیقات مقاومت های میکروبی تنها مرکزی است؛ که توانسته کشت ویروسی هپاتیت C را در کشور انجام دهد این موفقیت در حالی رخ می دهد که بسیاری در کشور در پروسه اولیه کار تولید، متوقف مانده اند؛ اما ما توانستیم از این قسمت عبور و به ویروس تولیدی دست پیدا کنیم.
رییس مرکز تحقیقات مقاومت های میکروبی دانشگاه علوم پزشکی مشهد، گفت: : مرکز تحقیقات مقاومت های میکروبی تنها مرکزی است؛ که توانسته کشت ویروسی هپاتیت C را در کشور انجام دهد این موفقیت در حالی رخ می دهد که بسیاری در کشور در پروسه اولیه کار تولید، متوقف مانده اند؛ اما ما توانستیم از این قسمت عبور و به ویروس تولیدی دست پیدا کنیم.
به گزارش وب دا؛ دکتر زهرا مشکات با اشاره به اقدامات در دست انجام این مرکز تحقیقات جهت ارائه گزارش جامع سه ساله مراکز تحقیقاتی دانشگاه علوم پزشکی مشهد، گفت: گروه میکروبیولوژی دانشکده پزشکی دانشگاه علوم پزشکی مشهد از گروه های بسیار قدیمی دانشگاه به شمار می رود و در دهه 1330 به همت دکتر میردامادی بنیانگذاری شده است.
وی افزود: از همان زمان دانشجویان مقاطع پزشکی و رزیدنتی توسط اعضای این گروه آموزش داده می شدند؛ که در ادامه دانشجویان مقاطع تحصیلات تکمیلی به این روند افزوده شد.
عضو هیأت علمی دانشگاه علوم پزشکی مشهد، تصریح کرد: دانشجویان تحصیلات تکمیلی در مقطع کارشناسی ارشد رشته های ویروس شناسی ومیکروبیولوژی پزشکی و مقطع PhD رشته باکتری شناسی پزشکی توسط گروه میکروبیولوژی دانشگاه در این مرکز آموزش می بینند و در واقع تمام دانشکده های دانشگاه علوم پزشکی مشهد به نحوی دروسی را می گذرانند که باید توسط اساتید این گروه آموزش داده شوند.
این محقق دانشگاه علوم پزشکی مشهد ابراز داشت: در سال 1385 این نیاز احساس شد که با توجه به محدودیت هایی که برای گروه میکروب شناسی در بیمارستان قائم(عج) از نظر کمبود فضا و تجهیزاتی وجود داشت؛ توسعه گروه را تحت عنوان مرکز تحقیقات میکروبیولوژی ادامه یابد که در نهایت این مرکز تحت عنوان مرکز تحقیقات میکروب شناسی و ویروس شناسی به همت و تلاش اساتید گروه بخصوص دکتر جواد قناعت و استاد مرحوم جناب آقای دکتر علی صادقیان در سال 1385 راه اندازی شد.
رییس مرکز تحقیقات مقاومت های میکروبی دانشگاه علوم پزشکی مشهد تاکید کرد: به همت اساتید، مرکز در این مدت توانست تجهیزات خوبی را خریداری و راه اندازی نماید و بخش زیادی از نیاز محققان جوان و دانشجویان خود را به این واسطه تامین کند.
وی تصریح کرد: اهدافی که این مرکز داشته در مهمترین شکل آن در دو شاخه ویروس شناسی و میکروب شناسی است؛ که از مهمترین اهدافش در شاخه میکروبیولوژی کنترل بیماری سل به عنوان یکی از بیماری هایی است؛ که با پیدایش بیماران مبتلا به ایدز و HIV سلامت و بهداشت جهانی را بیش از پیش مورد تهدید قرار داده است .
دکتر مشکات تاکید کرد: مرکز تحقیقات مقاومت های میکروبی از جمله مراکزی است؛ که در خصوص سل حرفی برای گفتن دارد. خطر بروز و شیوع سل مقاوم به درمان که به آنتی بیوتیک های رایج و در دسترس پاسخ نمی دهد کشور ما را به شدت تهدید می کند و این در حالی است که میزان بروز بیماری سل در میان مردم نیز به حالت کنترل در نیامده است. .
عضو هیأت علمی دانشگاه علوم پزشکی مشهد، خاطر نشان کرد: بحث عفونت های بیمارستانی و مقاومت های دارویی از دیگر تلاش هایی است که در این مرکز در حال کار بر روی آن هستیم؛ متاسفانه در کشور ما با توجه به فرهنگ غلطی که در میان مردم رواج و منجر به خود درمانی در هنگام بروز بیماری می شود مقاوم شدن باکتری ها و میکروب ها در برابر آنتی بیوتیک ها افزایش پیدا کرده است.
این محقق دانشگاه علوم پزشکی مشهد، تاکید کرد: از طرفی برخی پزشکان قبل از آن که تشخیص عفونت را داشته باشند آنتی بیوتیک برای بیماران خود تجویز می کنند؛ که این امر نیز در مقاوم شدن باکتری ها در برابر آنتی بیوتیک ها اثر بسیاری داشته و موجب طولانی شدن پروسه درمان می شود.
وی ادامه داد: این شیوه نادرست موجب شده است که بسیاری از ژن های مقاوم در برابر آنتی بیوتیک ها در باکتری های موجود در جامعه گردش داشته باشند. به نحوی که تعداد ژن های مقاوم به نسبت تحقیقات این مرکز در پنج سال گذشته بسیار بیشتر شده اند.
دکتر مشکات خاطر نشان کرد: بخش دیگری از تحقیقات مرکز در خصوص عفونت های بیمارستانی است که عفونت های بیمارستانی بدین معنا است که بیمار برای درمان بیماری دیگر وارد بیمارستان می شود؛ اما در بیمارستان درگیر عفونت های بیمارستانی شود.
عضو هیأت علمی دانشگاه علوم پزشکی مشهد، خاطر نشان کرد: در زمینه ویروس شناسی نیز تحقیقات زیادی در خصوص ویروس هپاتیت C، ژن های آنفولانزایی و HIV در حال انجام است؛ که با توجه به تجهیزات مورد نیاز برای انجام کار تحقیقاتی بر روی عوامل بیماریزای تنفسی مانند ویروس های آنفولانزا و سل ؛ با مساعدت ها و پیگیری های معاونت پژوهشی دانشگاه و قول های مساعد معاون پژوهشی دانشگاه به دنبال ایجاد یک مرکز ببوسیفتی سطح سه زیر نظر این مرکز تحقیقات هستیم؛ تا بتوانیم بر روی عفونت های تنفسی تحقیقات خود را توسعه دهیم.
وی اظهار داشت: این مرکز تحقیقات تاکنون مطالعات فراوانی در زمینه تولید واکسن ضد سل داشته است که در این زمینه محققان فرایند تولید واکسن خود را تا فاز حیوانی پیش می برند و ادامه نیاز به این مرکز بیوسیفتی سطح 3 می باشد تا بتوان کار تحقیقاتی را ادامه داد. بطور مثال تعداد زیادی واکسن های جدید پروتئینی نوترکیب یا واکسن های DNA علیه سل طراحی شده که تا مرحله تزریق به حیوان پیش رفته است اما تا بررسی بر روی حیوان آلوده شده انجام نگیرد نمی توان از اثر بخشی آن اطمینان حاصل کرد.
این محقق دانشگاه علوم پزشکی مشهد بیان داشت: واکسن هایی که در این مرکز تحقیقات بر روی آن ها کار تحقیقاتی می شود در دو نوع پیشگیری و درمانی است. به خصوص در مورد بیماری سل که واکسن «ب س ژ» تنها واکسن پیشگیری این بیماری در بازار است که ایمن زایی آن بسیار متغیر است و در بسیاری از جوامع ایمن زایی مناسب را نداشته است.
وی خاطر نشان کرد: میکروب سل حداقل سه ماه در خلط بیمار و در سایه زنده می ماند و می تواند در تمام این مدت دیگران را در معرض خطر قرار دهد. لذا، یکی از بهترین راه ها جهت جلوگیری از شیوع این بیماری در جامعه آموزش مستمر و صحیح به مردم می باشد.
این محقق دانشگاه علوم پزشکی مشهد گفت: بر اساس آمارها از هر سه نفر یک نفر باسیل سل را به صورت نهفته در بدن خود دارد و هر زمانی که سطح ایمنی بدن کاهش یابد قادر است فعال شده و بیماری سل فعال را ایجاد نماید.
رییس مرکز تحقیقات مقاومت های میکروبی دانشگاه علوم پزشکی مشهد، تاکید کرد: زمینه تحقیقاتی مهم دیگر در میکروبیولوژی بحث باکتری های مقاوم به آنتی بیوتیک ها مانند پسودوموناس ها یا آسینتوباکترها در بخش های سوختگی ها می باشد.
وی تصریح کرد: در زمینه ویروس شناسی مرکز تحقیقات مقاومت های میکروبی تنها مرکزی است؛ که توانسته کشت ویروسی هپاتیت C را در کشور انجام دهد.
دکتر مشکات به انجام کار تحقیقاتی جهت تولید داروی گیاهی درمان بیماری های ویروسی اشاره کرد و گفت: با دانشکده طب سنتی دانشگاه در حال همکاری هستیم تا داروهایی که در طب سنتی بر روی بیماری هپاتیت تاثیر دارد را شناسایی و بررسی نماییم و سپس بر روی ترکیبات آن دسته از داروهایی که پاسخ می دهد کار کنیم.
عضو هیأت علمی دانشگاه علوم پزشکی مشهد تاکید کرد: در مرحله های بعد تلاش داریم اگر بشود دارویی از گیاهان بومی کشور با قیمت مناسب نسبت به داروهای خارجی تولید شود. در حال حاضر مرحله آزمایش تعداد زیادی از گیاهان دارویی را در دست اقدام داریم و امیدوار هستیم تا با تولید داروی بومی از گرانی و بار مالی تحمیل شده به مردم بکاهیم. که علاوه بر این که به بیمار کمک می کند تا از عهده هزینه آن بر آید دارای اثر بخشی بیشتر و عوارض جانبی کمتر باشد.
دکتر مشکات در بخش پایانی صحبت های خود در خصوص امکانات مرکز تحقیقات مقاومت های میکروبی، تاکید کرد: 9 عضو شورای عالی مرکز در کنار ما فعالیت می کنند؛ در حقیقت این جا مرکزی است برای انجام پایان نامه های دانشجویان و هیچ محدودیتی برای حضور دانشجویان حتی در روزهای تعطیل وجود ندارد.
عضو هیأت علمی دانشگاه علوم پزشکی مشهد تصریح کرد: مرکز در بحث امتیاز دهی در بین 100 مرکزی که در وزارت بهداشت موافقت اصولی داشتند؛ رتبه 16 را با کسب 860 امتیاز به دست آورده و سال گذشته 25 مقاله ISI، 12 مقاله پاپمد و حدود 10 مقاله اسکوپوس تولید کرده است.
وی از حضور 70 دانشجوی تحصیلات تکمیلی در این مرکز تحقیقات برای گذراندن کار تحقیقاتی و پایان نامه خود خبر داد و اضافه کرد: دستگاه پالس فیلد با حدود 100 میلیون تومان اعتبار از سوی دانشگاه علوم پزشکی مشهد برای این مرکز خریداری شده است؛ که در شمال شرق کشور تنها دستگاه پالس فیلد می باشد و به خصوص دانشجویان PhD باکتری شناسی می توانند استفاده بسیاری از این دستگاه در تحقیقات اپیدمیولوژیک خود داشته باشند.
رییس مرکز تحقیقات مقاومت های میکروبی دانشگاه علوم پزشکی مشهد، چشم انداز این مرکز تحقیقات را بر تولید محصول متمرکز دانست و یادآور شد: در بخش باکتری در بررسی مقاومت های آنتی بیوتیکی تشخیص و واکسن سل متمرکز هستیم و در بخش ویروس شناسی مطالعات مرکز بر هپاتیت ها، پاپیلوما ویروس ها و HIV متمرکز شده است که امیدواریم تلاش ما بتواند در آینده ای نزدیک به ثمر نشیند و اثرات آن کاهش دهنده آلام بیماران ما باشد.









